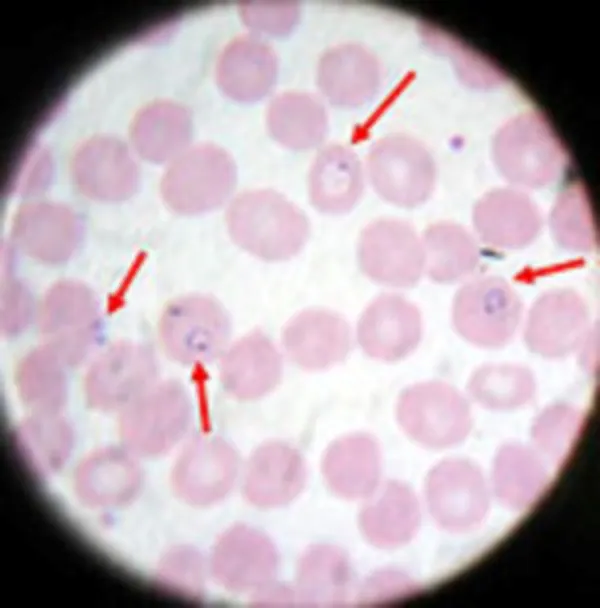
Blood smear showing plasmodium falciparum parasites

At a glance
- Microscopic examination of blood films is the gold standard for laboratory confirmation of malaria parasites.
- A Rapid Diagnostic Test (RDT) is an alternate way of quickly establishing the diagnosis of malaria.
- PCR can help identify the Plasmodium species to ensure proper treatment.
Microscopy
Microscopic examination remains the "gold standard" for laboratory confirmation of malaria. These tests should be performed by an experienced microscopist immediately when ordered by a healthcare provider. They should not be saved or batched for convenience. In addition, for initial malaria screening, these tests should not be sent out to reference laboratories with results available only days to weeks later. It is vital that health-care providers receive results from these tests within hours in order to appropriately treat their patients infected with malaria.
Technique
(See DPDx specimen preparation) A blood specimen collected from the patient is spread as a thick or thin blood smear, stained with an appropriate stain (e.g. Giemsa, Wright-Giemsa), and examined with a 100X oil immersion objective. Visual criteria are used to detect malaria parasites and to differentiate (when possible) the various species. (See DPDx Plasmodium species comparison chart)
Advantages
Malaria microscopy is a well-established method requiring minimal, widely available equipment, supplies, and reagents. Within a few hours of collecting the blood, the microscopy test can provide valuable information. First and foremost, it can determine that malaria parasites are present in the patient's blood. Once the diagnosis is established—usually by detecting parasites in the thick smear—the microscopist can examine the thin smear to determine the malaria species and the parasitemia, or the percentage of the patient's red blood cells that are infected with malaria parasites. The thin and thick smears examined in conjunction are able to provide all 3 of these vital pieces of information to the healthcare provider to guide the initial treatment decisions that need to be made acutely.
Resource
Disadvantages
Microscopy results are only as reliable as the laboratories performing the tests. In the United States, there are 2,000 cases of malaria diagnosed and reported in a typical year. Thus, many laboratories may not perform this test regularly or may not maintain capacity. A negative blood smear makes the diagnosis of malaria unlikely. However, because non-immune individuals may be symptomatic at very low parasite densities which may be initially undetectable, blood smears should be repeated every 12 – 24 hours for a total of three sets before the diagnosis of malaria can be ruled out.
Rapid Diagnostic Test
A Rapid Diagnostic Test (RDT) is an alternate way of quickly establishing the diagnosis of malaria infection by detecting specific malaria antigens in a person's blood. One RDT (BinaxNow®) is FDA approved in the United States for use by clinical laboratories.
Technique
A blood specimen collected from the patient is applied to the sample pad on the test card along with certain reagents. After 15 minutes, the presence of specific bands in the test card window indicates whether the patient is infected with Plasmodium falciparum and/or at least one of the other three species of human malaria. It is recommended that the laboratory maintain a supply of blood containing P. falciparum for use as a positive control.
Advantages
High-quality malaria microscopy is not always immediately available in every clinical setting where patients might seek medical attention. In such settings, laboratories may use an RDT to more rapidly determine if their patients are infected with malaria.

Disadvantages
The use of the RDT does not eliminate the need for malaria microscopy. The RDT may not be able to detect some infections with lower numbers of malaria parasites circulating in the patient's bloodstream. Also, there is insufficient sensitivity data available to determine the ability of this test to detect the 2 less common species of malaria, P. ovale and P. malariae. Therefore, all negative RDTs must be followed by microscopy to confirm the result.
In addition, all positive RDTs also should be followed by microscopy. The currently approved RDT detects 2 different malaria antigens; one is specific for P. falciparum and the other is found in all 4 human species of malaria. Thus, microscopy is needed to determine the species (one or more) of malaria that was detected by the RDT. In addition, microscopy is needed to quantify the proportion of red blood cells that are infected (parasitemia density), which is an important prognostic indicator.
Training
The FDA approved rapid diagnostic test (RDT) for use in the United States is Binax NOW Malaria. This RDT is approved for use by clinical laboratories, not by individual clinicians or by patients themselves. This video provides guidance regarding the test procedure and results interpretation.
Molecular Detection
Parasite nucleic acids are detected using polymerase chain reaction (PCR). Although this technique may be more sensitive than blood smear microscopy, it is of limited utility for the diagnosis of acutely ill patients in the standard healthcare setting. PCR results are often not available quickly enough to be of value in establishing the diagnosis of malaria infection.
PCR is most useful for confirming the species of malarial parasite after the diagnosis has been established by either smear microscopy or RDT.